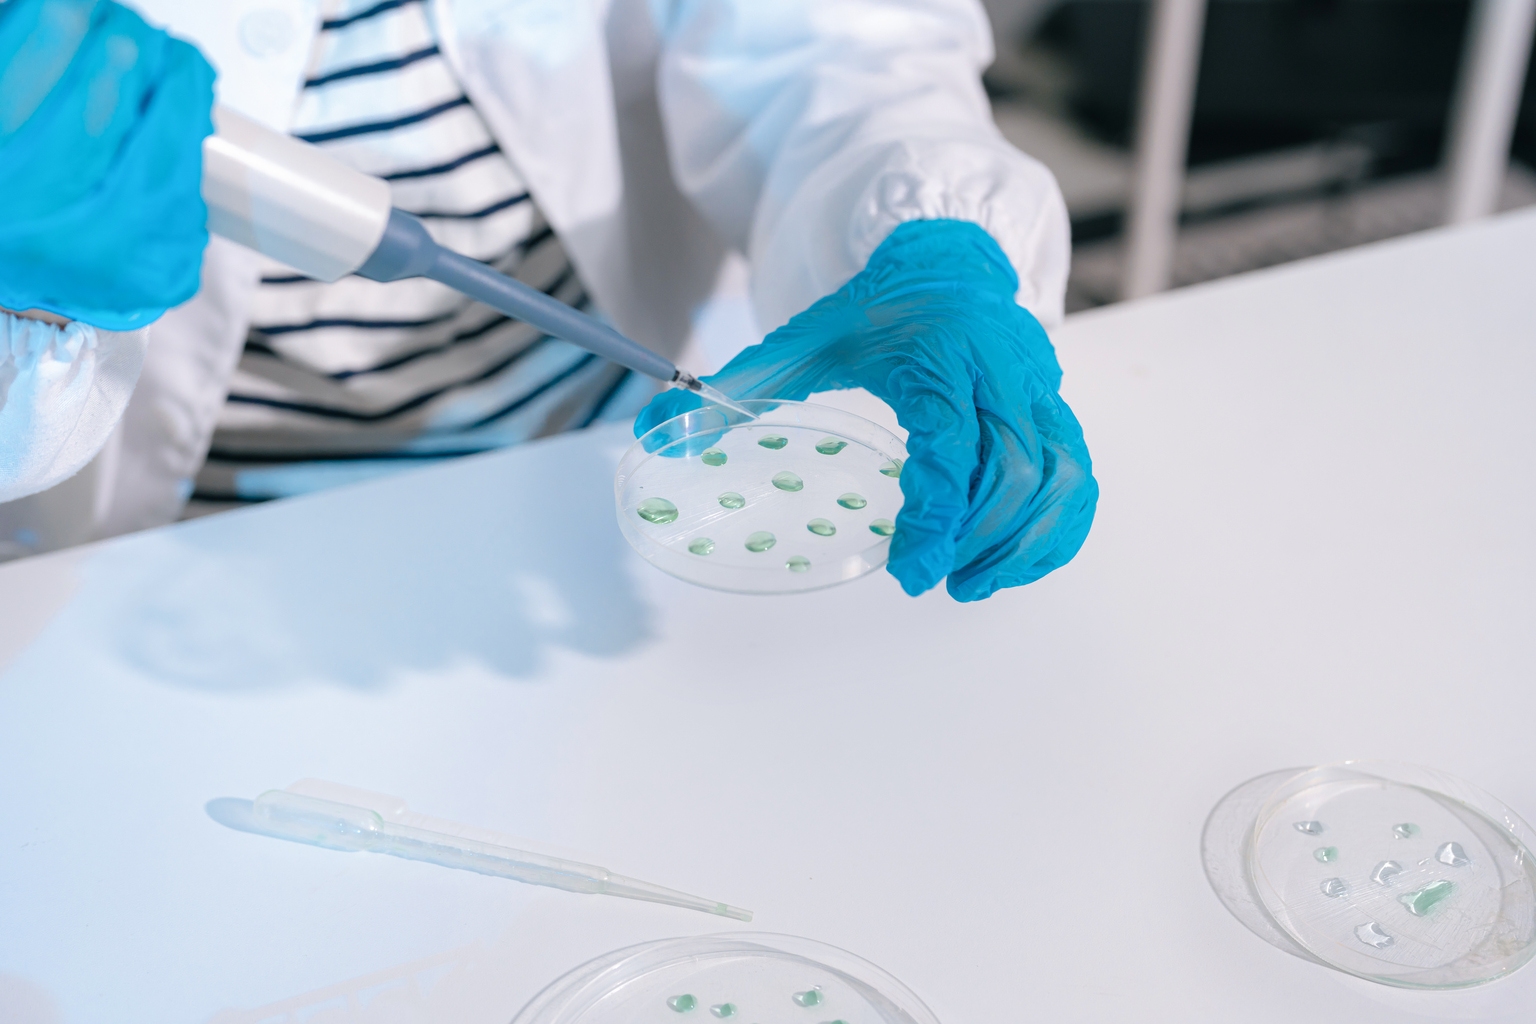
Voyager Therapeutics: Why Clinical Milestones Position VY7523 as a Strategic Biotech Play

Voyager Therapeutics: Why Clinical Milestones Position VY7523 as a Strategic Biotech Play
Voyager Therapeutics has positioned itself for significant growth through 2026 as its anti-tau antibody, VY7523, demonstrates strong clinical safety and pharmacokinetic performance.
Clinical Validation and the Path to 2026
Voyager Therapeutics (VYGR) has reached a critical juncture following the release of Phase 1 single ascending dose (SAD) data for its anti-tau monoclonal antibody, VY7523. The study results have bolstered investor confidence, establishing the asset as a focal point for the company's valuation heading into 2026. By demonstrating an excellent safety profile and robust pharmacokinetic (PK) performance, the company has cleared a significant hurdle in the development of treatments targeting Alzheimer’s disease (AD).
Investors conducting stock market analysis should note that clinical-stage biotech firms often derive their primary value from these early-phase proof-of-concept milestones. The successful completion of the SAD trial not only validates the underlying science but also de-risks the platform as it moves toward more complex clinical evaluations.
Data Highlights and Asset Potential
The primary appeal of VY7523 lies in its performance metrics observed during the initial testing phases. Management has emphasized that the data supports a favorable therapeutic window, which is essential for long-term administration in neurodegenerative patient populations.
Key Clinical Observations
- Phase 1 SAD Success: The study met its primary safety endpoints with no significant adverse reactions reported.
- Optimized PK Profile: The antibody demonstrated stability and bioavailability levels that align with best-in-class expectations for monoclonal therapies.
- Strategic Focus: The drug is specifically engineered to address the tau pathology associated with Alzheimer’s disease.
"The excellent safety and PK profile demonstrated in the Phase 1 SAD trial provides a clear roadmap for the continued clinical advancement of VY7523 through 2026," noted industry analysts tracking the progress of the program.
Comparative Performance Metrics
To understand the competitive landscape of neurodegenerative pipelines, it is helpful to compare the progress of emerging assets like VY7523 against standard sector benchmarks. While individual trials vary, the following table summarizes the key developmental markers for Voyager Therapeutics.
| Metric | Status / Finding |
|---|---|
| Phase 1 SAD Safety | Excellent |
| PK Profile | Robust/Optimized |
| Primary Target | Tau Protein (Alzheimer's) |
| Milestone Year | 2026 |
Market Implications for Biotech Traders
For those utilizing the best stock brokers to build positions in the healthcare sector, Voyager Therapeutics represents a high-conviction play on neuro-innovation. The stock has been designated a Strong Buy by market observers who prioritize companies with clear upcoming inflection points. Traders should be aware that while the safety data is promising, the path to regulatory approval remains subject to the inherent volatility of clinical trial results and broader biotech sector sentiment.
Similar to how Walmart’s Drone Expansion Signals a Pivotal Shift in Retail Logistics, Voyager is attempting to shift the standard of care within its specific niche. Investors should monitor the company’s capital allocation and potential partnerships as they ramp up for more intensive Phase 2 studies.
Forward-Looking Outlook
As the company targets 2026 for major data readouts and subsequent inflection points, the primary focus for stakeholders will be the progression of the VY7523 program. The transition from SAD data to multi-dose studies will be the next major catalyst. Market participants should watch for updates on dosing schedules and any early signals of cognitive impact, which will be the ultimate determinants of the drug's market potential and the company's long-term enterprise value.